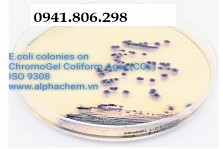
../view-223x149/moi-truong-chromogel-coliform-agar-iso-93081_p_2707.jpg

|
CÔNG TY TNHH THIẾT BỊ QUANG HUY Điện thoại: 0968.802.799 - Hotline: 0941.806.298 Địa chỉ: Đồng Quang, Quốc Oai, Hà Nội Website: http://www.thietbiquanghuy.com Email: quanghuy.tbhn@gmail.com |
|
BẢNG BÁO GIÁ |
Thiết bị Quang Huy là đơn vị hàng đầu trong lĩnh vực Cân điện tử, Máy hút ẩm, Thiết bị Y tế. Quang Huy có một đội ngũ nhân viện nhiệt tình và đầy kinh nghiệp trong lĩnh vực này, do đó sẽ mang lại cho bạn sự an tâm trong việc lựa chọn các sản phẩm. Kính gửi quý khách báo giá sản phẩm
| Tên hàng | Thông tin chi tiết | Đơn giá/1(VNĐ) | VAT 10% | Thành Tiền | Bảo hành |
Môi trường ChromoGel Coliform Agar ISO 9308-1 |
Môi trường ChromoGel Coliform Agar ISO 9308-1 Môi trường nuôi cấy vi sinh tạo màu khuẩn lạc đặc trưng ChromoGel Coliform Agar dùng nuôi cấy e.coli coliform trong nước bằng phương pháp màng lọc theo ISO 9308-1. Sản phẩm được sản xuất bởi công ty Alphachem Việt Nam đóng gói dạng bột đông khô và đĩa thạch đỗ sẵn. CÔNG TY TNHH THIẾT BỊ QUANG HUY Địa chỉ: Xóm 3, Thôn Yên Nội, Xã Đồng Quang, Huyện Quốc Oai, TP Hà Nội VPGD: Số 83, ngõ 2 Hoàng Sâm, Cầu Giấy, Hà Nội Tel: 024.62601828 - Hotline: 0903.268.919- 0941.806.298
|
0 | 0 | Vui lòng liên hệ | 12 tháng |
Ghi Chú :
- Báo giá trên đã bao gồm thuế VAT 10%
- - Giá cả có thể thay đổi tùy theo thị trường mà không kịp báo trước
Thanh toán :
- - Bằng tiền mặt hoặc chuyển khoản.
- - Tài khoản VND: 60013449 tại Ngân Hàng Á Châu chi nhánh Liễu Giai - Hà Nội.
- - Đơn vị thụ hưởng: Công ty TNHH Thiết bị Quang Huy